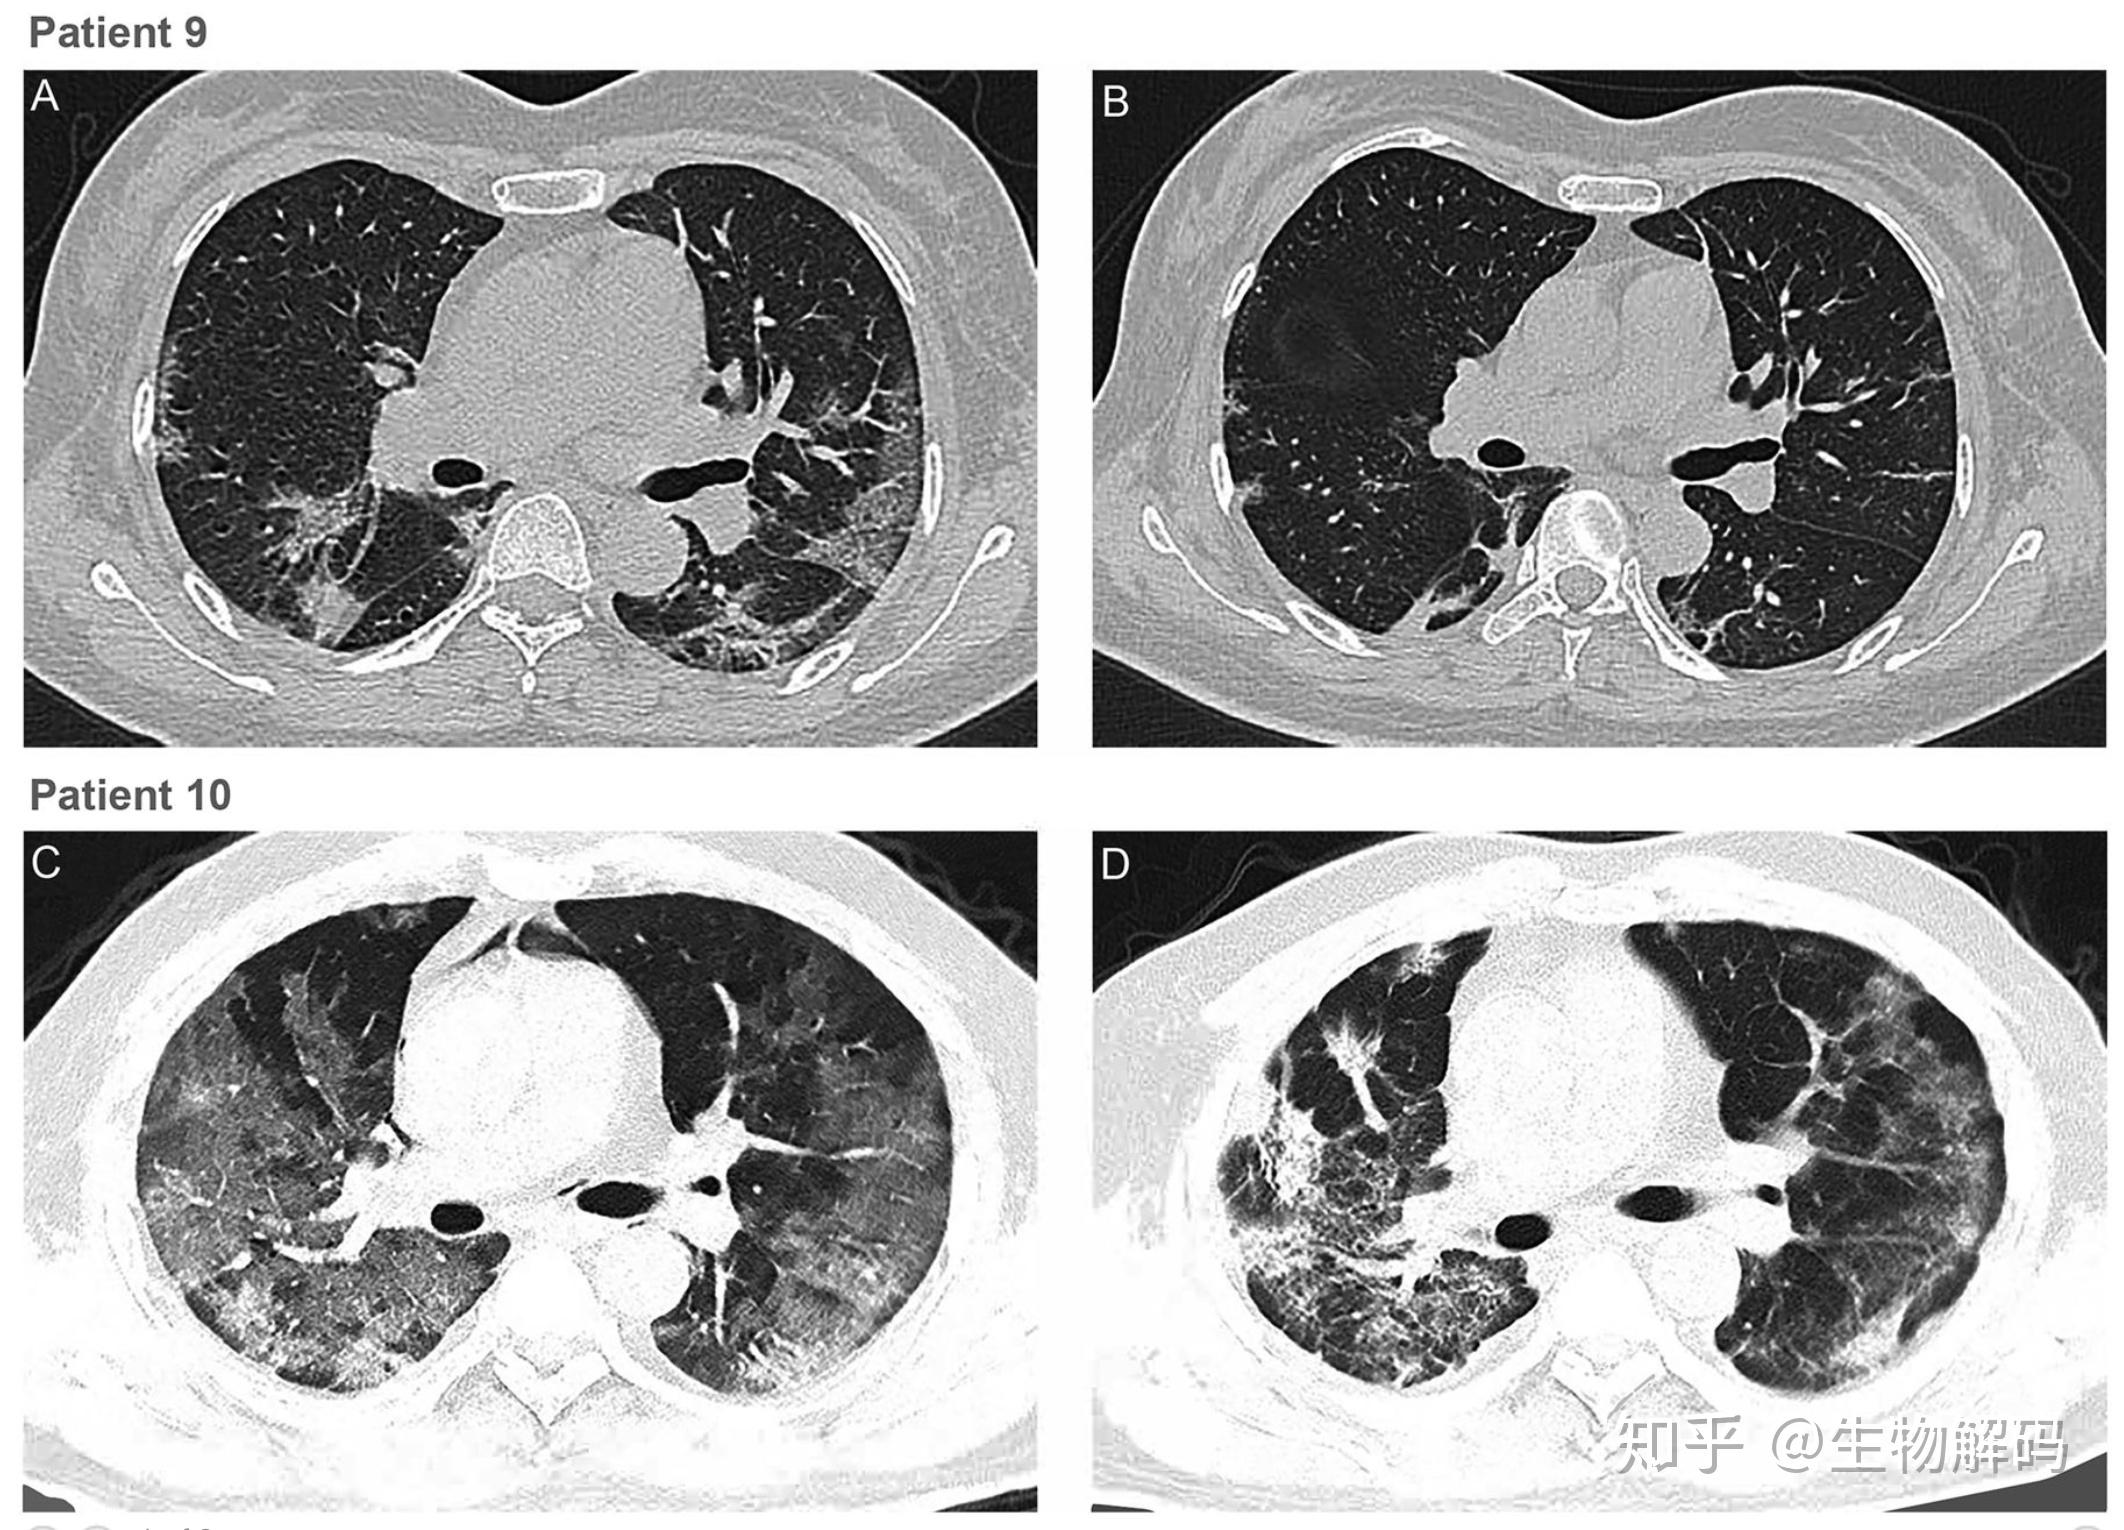
在这项工作中,作者探索了恢复性血浆(convalescent plasma)输血抢救

convalescent plasma

美国fda 紧急授权使用 convalescent plasma 康复患者的血浆治疗新冠
图片尺寸1920x1080
又称武汉肺炎,新冠肺炎)康复患者的恢复期血浆(convalescent plasma)
图片尺寸700x478
convalescent plasma antibody levels and the risk of death from
图片尺寸1800x1077
rwjbarnabas health seeks donors of convalescent plasma for its
图片尺寸534x462
内环线英语超话convalescentplasma
图片尺寸640x360
updated guidance for covid-19 convalescent plasma use from the
图片尺寸533x324
convalescent plasma therapy proves effective on severe covid-19
图片尺寸700x400
cuba adds convalescent plasma as part of its treatments to save
图片尺寸780x400
from patient to lifesaver: convalescent plasma donor steps up to
图片尺寸1200x1270
灌输,浸泡46615plasma:n. 原浆,原生质66615convale
图片尺寸1080x820
study by icap researchers on covid-19 and convalescent plasma
图片尺寸1201x900
science解谜:肠道微生物如何帮助免疫系统攻击癌性肿瘤?
图片尺寸744x771
zhux2.com/editor1506673103858594.jpg
图片尺寸958x1000
如何看待美股吉利德科学盘中大跌暂停交易报道称瑞德西
图片尺寸914x1122
《细胞》:中国科学家发现治疗新冠强效药!
图片尺寸1080x1139
联盟向治愈者征集血浆三球员还未回应为国出力等同于推进复赛
图片尺寸614x619
新冠病毒针对单克隆抗体药出现变异进化需关注免疫低下群体
图片尺寸1646x2026
在这项工作中,作者探索了恢复性血浆(convalescent plasma)输血抢救
图片尺寸2124x1530
论坛
图片尺寸1194x634
science | 新冠康复者体内含有针对13种天然sars-cov-2变体的超级抗体
图片尺寸1080x612